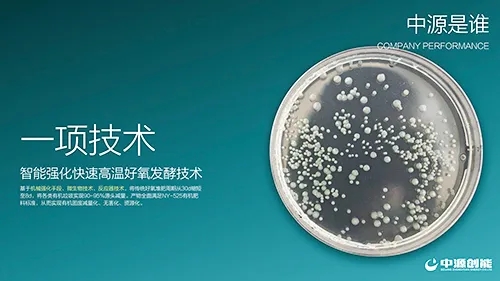
25.jpg

5月29日,中国环境卫生协会有机固废专业委员会举办了关于“厨余垃圾处理技术与模式探讨”为主题的一期在线沙龙,行业专家、环保企业代表及媒体人出席了本次沙龙。北京中源创能工程技术有限公司(下称中源创能)创始人阎中博士发表讲话并同与会嘉宾针对厨余垃圾处理技术与模式进行了深入交流与分享。
谈到技术
中源创能创始人阎中博士认为我国餐厨垃圾处理行业获得了巨大发展。通过不断的研发和实践,以厌氧消化为核心的集中处理模式是被证实的适合国情技术路线。
现在需要考虑的是下阶段,当我们的工作逐渐从餐饮服务机构产生的餐厨垃圾过渡为居民家庭产生的厨余垃圾的时候,应该如何面对技术与模式的选择。

北京中源创能工程技术有限公司创始人阎中博士于在线沙龙现场发言。( Sinoenc)
首先要认清厨余垃圾和餐厨垃圾的差别。
厨余垃圾的含水率要比餐厨垃圾低,但是二者固含量相差巨大,同时厨余垃圾的含油量更低,含盐量更低。因此,技术路线需基于厨余垃圾的性质特征。

图为厨余垃圾与餐厨垃圾成分含量对比。(Sinoenc)
阎中认为,可能获得成功的技术路线有三条:
第一传统湿式厌氧消化技术路线需要优化提升。
由于不需要再进行提油,热水解和三相分离环节在厨余垃圾过程中的重要性会下降,固液分离之后液体浆料直接进入厌氧消化。湿式厌氧需要做的工作是在前端进行强化水解,让尽可能多的有机质通过生物转化之后进入到液相,提高厨余垃圾中有机质的资源化利用和无害化处理。
第二好氧发酵技术的重要性会大幅提升。
餐厨垃圾处理过程中,前端产生的固相产物约10-20%,量少且以无机物为主,行业常见的处置方式是填埋或焚烧。相比餐厨垃圾,厨余垃圾前期固相产物提升为50%或更高,且富含大量的有机质,仍采用焚烧或者填埋的传统方式处理有悖于垃圾分类的初衷,基于这种情况,第二条可能会成功的技术路线,就是液形物通过厌氧消化进行处理,固形物采用好氧堆肥的方式进行处理,从而实现厨余垃圾有机质的全量生物转化。
第三干发酵也是一条可选的工艺路线。
相比湿式厌氧,干发酵的工艺路线更短,且沼液产生量大幅降低,干发酵需要优化的方向是传质、传热、容积产气率、产物利用等问题。
概括一下,下一阶段基于餐厨垃圾和厨余垃圾性质的区别,强化水解高干固液分离加实施厌氧消化技术路线的升级,干发酵,以及好氧发酵技术路线将体现重要性。

厨余垃圾与餐厨垃圾物料性质的差异。(Sinoenc)
以上这三条工艺路线,其实都是有一个核心的逻辑,就是固相有机质与液相有机质的定向精准分配,以此为基础分别匹配高效的固液处理技术是核心的关键问题。

中源创能创始人阎中博士参与在线沙龙与业内人士共同探讨相关话题。(Sinoenc)
谈到分散处理
分散处理不是一个单纯的技术,阎中博士表示,分散处理需要技术、装备、特别是模式的支撑。
技术方面,基于厨余垃圾的物料性质,他们开发了智能强化的快速高温好氧发酵技术。通过机械的手段,反应器的技术,微生物的技术将传统好氧堆肥的时间从原来的30天缩短到8天左右。在源头实现90%至95%的减量。
智能强化快速高温好氧发酵技术。(Sinoenc)
装备方面,在装备开发的过程中实现小型化,小型设备的占地面积缩短到十个平米以内。可针对不同的区域去灵活的匹配和应用这样的项目。例如地下车库、厂房,甚至一个停车位。随产随收随处理不对环境造成任何其他影响。

有机垃圾生物发酵反应器。(Sinoenc)
实际应用,以江阴市为例,通过大量调研,规划了1座80吨的集中式餐厨垃圾处理设施,20吨的果蔬垃圾处理设施。同时在各个乡镇规划14座6吨到16吨不等的厨余垃圾终端处理设施,总的处理规模达到250吨。
基于合理规划高效的分配了集中+分散的终端处理格局,单体处理规模大幅降低,占地面积缩小,所有项目全部建在现有的中转站或垃圾处理设施内,没有新增征地。降低了项目的实施难度。

中源创能有机垃圾处理车间。(Sinoenc)
未来展望,阎中博士认为,从2017年开始,我国生活垃圾处理的体系将会产生第二次巨大变革,现在行业有大量专业、务实的专家和企业,在相关领域开展了长期、大量的探索和实践,他们很有信心也希望中源创能近10年所做的这些探索和实践,能够为下一阶段我国垃圾分类工作的开展贡献一份力量。
THE END
